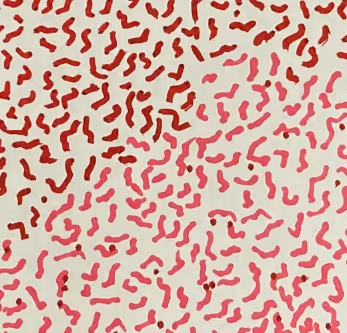
Energy Vibrations by Karrie Ross - old

CONTACT me to buy unlisted NFTs https://www.karrieross.com "What is your energy telling the world? Are you listening?" linktr.ee/KarrieRoss
CONTACT me to buy unlisted NFTs https://www.karrieross.com "What is your energy telling the world? Are you listening?" linktr.ee/KarrieRoss